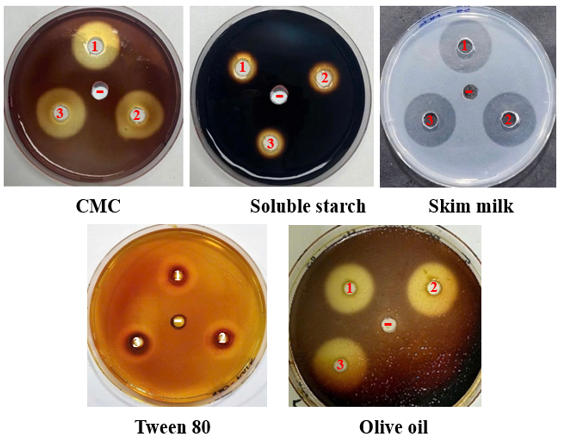

Biological characteristics and environmental application potential of Bacillus velezensis TSD5 isolated from a coral island soil in Khanh Hoa Province, Vietnam
Department of Biotechnology, Joint Vietnam-Russia Tropical Science and Technology Research Center
63 Nguyen Van Huyen stress, Nghia Do ward, Hanoi, Vietnam
Phone: +84 982060429; Email: huelebiotech85@gmail.com
Main Article Content
Abstract
Halotolerant bacteria play vital roles in saline ecosystems, particularly in extreme habitats such as offshore coral island soils in Khanh Hoa Province, Vietnam. In this study, an indigenous strain, Bacillus velezensis TSD5, was characterized for its extracellular enzymatic, plant growth-promoting, and stress-tolerance traits. The strain produced a substantial amount of indole-3-acetic acid (IAA, 12.76 mg/L), exceeding levels reported for reference strains and thereby highlighting its potential role in stimulating plant root development under saline conditions. Extracellular enzyme analysis revealed strong cellulolytic (17.49 mm) and lipolytic (17.76 mm on olive oil) activities, along with amylase (8.15 mm) and protease (10.27 mm) activities, suggesting broad substrate-degradation capabilities relevant to soil nutrient cycling. In addition, TSD5 demonstrated the ability to degrade hydrocarbons, with halo diameters of 16.65 mm and 27.05 mm on diesel and crude oil, respectively, indicating its capacity to contribute to bioremediation in oil-contaminated environments. Stress-tolerance assays showed that TSD5 was able to survive up to 12.5% NaCl and 10% MgSO₄, confirming its marked halotolerance. The strain also displayed high tolerance to Pb(CH₃COO)₂ (900 µg/mL), ZnCl₂ (750 µg/mL), and FeSO₄ (750 µg/mL) but was more sensitive to Hg(NO₃)₂, Cd(NO₃)₂, NaAsO₂, and Cr(NO₃)₃, with thresholds ranging from 8–16 µg/mL. Together, these findings provide new insights into the ecological roles of EPS-producing halotolerant bacteria from offshore coral islands and underscore their potential applications in agriculture, bioremediation, and biotechnology under saline- and metal-stressed conditions. The ability of B. velezensis TSD5 to simultaneously withstand salt stress, promote plant growth, and degrade hydrocarbons highlights its promise as a multifunctional microbial resource for sustainable soil management and ecological restoration in polluted environments.
Keywords
Hydrolytic enzymes, indole-3-acetic acid, hydrocarbon degradation, heavy-metal tolerance, exopolysaccharides, halotolerance
Article Details

This work is licensed under a Creative Commons Attribution 4.0 International License.
- Highlights:
Bacillus velezensis TSD5 exhibits a diverse range of biological characteristics, including remarkable tolerance to salinity and heavy metals, efficient degradation of organic macromolecules, and notable phytohormone production.
The strain efficiently degrades petroleum hydrocarbons, supporting sustainable bioremediation strategies.
Bacillus velezensis TSD5 enhances nutrient cycling and plant–microbe interactions through its enzymatic and metabolic versatility, demonstrating strong potential for bioformulation development, soil fertility improvement, and ecological restoration in saline and polluted coastal ecosystems.
1. INTRODUCTION
Salt-tolerant bacteria are indispensable components of saline ecosystems, particularly in extreme habitats such as offshore coral island soils, where high salinity, arid conditions, intense solar radiation, and limited nutrient availability prevail. These microorganisms have evolved diverse adaptive mechanisms, including exopolysaccharide (EPS) production, osmoprotectant synthesis, and extracellular enzyme secretion, which enable them to survive under osmotic stress and nutrient scarcity. Among them, members of the genus Bacillus are particularly noteworthy due to their metabolic versatility, capacity for EPS production, high adaptability to diverse ecological conditions, and multiple plant growth–promoting functions[1–5].
Bacillus velezensis is a Gram-positive bacterium well-known for its antimicrobial activity, hydrolytic enzyme secretion, phytohormone production, exopolysaccharide biosynthesis, and resistance to both heavy metals and hydrocarbons [1,3,6,7]. These traits not only contribute to nutrient cycling, soil structure improvement, and plant–microbe interactions but also highlight its value in bioremediation. Notably, the ability of B. velezensis to degrade oil under saline conditions and to withstand multiple heavy metals underscores its potential for integrated remediation of co-contaminated environments, particularly in fragile marine and island ecosystems where conventional approaches are limited [8–11].
Coral islands in Khanh Hoa Province, Vietnam, are characterized by high salinity, alkalinity, aridity, intense solar radiation, and nutrient deficiency, making them a unique reservoir for extremotolerant microbes. Previous research identified an indigenous strain, B. velezensis TSD5, which tolerates NaCl up to 12.5% and produces 1.25 g/L EPS under 3% NaCl stress [5]. Building upon these findings, the present study further investigates the strain’s extracellular hydrolytic enzyme activities, indole-3-acetic acid (IAA) production, hydrocarbon degradation potential, and tolerance to salt and heavy metals. These functional traits are expected to play key roles in nutrient turnover, stress adaptation, and biotechnological applications, with implications for sustainable soil management and ecological restoration in vulnerable offshore island ecosystems.
2. RESEARCH MATERIALS AND METHODOLOGY
2.1. Research materials
The salt-tolerant, EPS-producing strain Bacillus velezensis TSD5 was isolated from the soil of a coral island in Khanh Hoa Province, Vietnam [5]. The strain was preserved in 38% (v/v) glycerol at –85°C.
2.2. Research methodology
2.2.1. Cultivation of bacterial cells
The bacterial strain was cultivated in Luria–Bertani (LB) medium at 30°C with agitation at 150 rpm for 48 h (for the IAA production assay, LB medium was supplemented with 5 mM tryptophan [6]). The culture broth was then centrifuged at 12,000 rpm for 10 min to obtain a cell-free supernatant, which was subsequently used to assess extracellular enzyme activity, hydrocarbon-degrading ability, and IAA production.
2.2.2. Determination of bacterial IAA production
The determination of IAA production by the bacterial strain was based on the Salkowski colorimetric reaction. Samples containing IAA develop a characteristic reddish color upon reaction, which can be quantified spectrophotometrically at 535 nm. The assay was performed according to Lebrazi et al. (2020) [12]. The supperntant was mixed with Salkowski reagent (prepared from 1 mL of 0.5 mol/L FeCl₃ and 49 mL of 35% HClO₄) at a ratio of 1:2 (v/v). The mixtures were incubated in the dark at 28 ± 2°C for 30 min. The IAA concentration was estimated using a standard calibration curve ranging from 10 to 100 µg/mL. All measurements were performed in triplicate.
2.2.3. Determination of cellulase, amylase, protease, and lipase activities
Extracellular enzymatic activities were assessed using agar plates supplemented with the appropriate substrates, including carboxymethyl cellulose (CMC), soluble starch, skim milk, Tween 80, and olive oil. The addition of extracellular extracts containing substrate-degrading enzymes into agar wells resulted in the formation of clear hydrolytic zones following substrate degradation, which were visualized using Lugol’s iodine staining, except for skim milk plates where hydrolysis was directly observable without staining. These hydrolytic zones indicated substrate degradation by the enzymes, and the activity was determined as the difference between the total diameter of the hydrolytic zone and the diameter of the well.
The assays were performed according to previously described methods [6,13]. Briefly, 50 µL of cell-free supernatant was loaded into wells on LB agar plates containing 1% CMC, 0.5% soluble starch, or 2% skim milk. All experiments were conducted in triplicate. The plates were incubated at 30 °C for 24 h. After incubation, all plates except those containing skim milk were stained with 1% Lugol’s solution for 15 min, followed by removal of excess stain and observation of the clear hydrolytic zones. The diameters of the hydrolytic zones (mm) were measured to evaluate enzymatic activity.
Lipase activity was determined in a similar manner using LB agar supplemented with either 1% Tween 80 [14, 15] or 1% olive oil [16]. Tween 80, an ester and water-insoluble carbon source, can be hydrolyzed by lipase into oleic acid and polyoxyethylene sorbitol, leading to visible color changes in the medium after Lugol’s staining, thereby confirming the presence and activity of lipase.
2.2.4. Evaluation of hydrocarbon degradation
The assay was performed similarly to the cellulase activity test (CMC hydrolysis), except that the substrate was replaced with 1% crude oil or 1% diesel oil.
2.2.5. Oil spreading assay
The oil spreading assay was conducted as previously described [11]. Briefly, 20 µL of crude oil was added to the surface of a Petri dish containing 20 mL of distilled water, followed by the addition of either 10 µL of LB medium (negative control) or the extracellular extract on top of the oil layer. The displacement or spreading of the oil was then observed visually.
2.2.6. Evaluation of salt and heavy metal stress tolerance
The assay was conducted following the protocol described by Le et al. (2025) [3]. Salt tolerance was assessed using NaCl and MgSO₄ at concentrations ranging from 0 to 17.5%. Heavy metal tolerance was evaluated using Pb(CH₃COO)₂, FeSO₄, and ZnCl₂ at concentrations from 0 to 1050 µg/mL, and Cd(NO₃)₂, Hg(NO₃)₂, NaAsO₂, and Cr(NO₃)₃ at concentrations from 0 to 128 µg/mL.
3. RESULTS
3.1. Indole-3-acetic acid production by B. velezensis TSD5
In this study, B. velezensis TSD5 exhibited moderate IAA production, with a production level of 12.76 ± 0.12 mg/L under the specific experimental conditions tested (Table 1). This level of IAA production was markedly higher than that previously observed for the reference strain B. velezensis HMB26553 (9.7 mg/L) [6], but lower than that of strain QA2 (50 mg/L) [17]. However, its IAA level remained substantially lower than those reported for other bacteria, including Rhizobium (90.21 mg/L), Phyllobacterium (67.85 mg/L), Bacillus (83.54 mg/L), and Agrobacterium (74.3 mg/L) [12].
Table 1. Evaluation of IAA production of B. velezensis TSD5.

3.2. Extracellular enzyme production
Extracellular enzymatic activities of B. velezensis TSD5 were quantified by measuring clear-zone diameters on agar plates containing the appropriate substrates (Table 2, Figure 1). Bacillus velezensis TSD5 produced measurable hydrolytic halos for all tested enzymes. Mean clear-zone diameters (mean ± SD, mm) were recorded as follows: cellulase (CMC hydrolysis) 17.49 ± 0.21, amylase (starch hydrolysis) 8.15 ± 0.48, protease (skim milk hydrolysis) 10.27 ± 0.31, lipase (Tween 80) 7.61 ± 0.09, and lipase (olive oil) 17.76 ± 0.47 (Table 2).
Comparative data from previously characterized B. velezensis strains and other Bacillus spp. indicate that strain TSD5 exhibits substantially larger cellulolytic and olive-oil lipolytic halos than several reference strains. For example, B. velezensis HMB26553 and QA2 produced markedly smaller cellulase zones (reported 4.1 mm [6] and 5.41 mm [17], respectively). The proteolytic activity of strain TSD5 (10.27 mm) exceeded the reported clear-zone diameters for HMB26553 and QA2 (5.6 mm [6] and 1.15 mm [17], respectively). For lipolysis, olive-oil hydrolysis by TSD5 (17.76 mm) was larger than the 6 mm reported for B. amyloliquefaciens Ba-BPD1 [16], while Tween-80 lipase activity of TSD5 (7.61 mm) was lower than that of Bacillus strains previously reported (17–18 mm) [15], yet it still demonstrated an active lipolytic capacity.
Table 2. Extracellular enzymatic activities of B. velezensis TSD5.

Figure 1. Evaluation of extracellular enzymatic activities of the culture supernatant of Bacillus velezensis TSD5 (1-3), with LB medium (–) serving as the control.
3.3. Hydrocarbon degradation potential
The extracellular culture supernatant of B. velezensis TSD5 exhibited measurable hydrocarbon-degrading activity against both diesel oil and crude oil, as indicated by the clear zone diameters surrounding the sample wells (Table 3, Figure 2). The mean halo diameters were 16.65 ± 0.35 mm for diesel oil and 27.05 ± 0.21 mm for crude oil. In the oil spreading assay, the addition of the extracellular extract onto the oil surface produced a transparent zone that expanded to approximately 45 mm before rupturing after about 23 seconds. A similar spreading and disruption of the oil droplet were observed for Bacillus methylotrophicus OB9 [18]. However, in other assays, the droplet spread but did not rupture, as in the case of extracellular extracts from Candida parapsilosis, where the spreading diameter reached only 9.7 ± 1.1 mm on the crude oil surface [11]. These results indicate that B. velezensis TSD5 secretes extracellular metabolites, potentially including biosurfactants and hydrolytic enzymes, that are capable of partially degrading petroleum hydrocarbons.
Table 3. Hydrocarbon degradability of the extracellular culture supernatant of B. velezensis TSD5.


Figure 2. Hydrocarbon degradation assay using the extracellular culture supernatant of B. velezensis TSD5 (1–3), with LB medium (–) as the control.
3.4. Salt and heavy metal tolerance
The salt and heavy metal tolerance of B. velezensis TSD5 is presented in Table 4 and Figure 3. The strain exhibited substantial halotolerance, withstanding NaCl concentrations up to 12.5% (as previously reported by Le et al. [5]) and MgSO₄ up to 10%. Regarding heavy metals, TSD5 showed the highest tolerance to Pb, sustaining growth at concentrations up to 900 µg/mL, followed by Zn and Fe, both tolerated at levels up to 750 µg/mL. In contrast, the strain was markedly less resistant to other metals, with tolerance thresholds of 16 µg/mL for Hg and As and only 8 µg/mL for Cd and Cr.
Table 4. Salt and heavy metal stress tolerance of B. velezensis TSD5


Figure 3. Visualization of the growth capacity of B. velezensis TSD5 under different stress conditions: NaCl/MgSO₄ ranging from 0–17.5% (a), Pb/Zn/Fe ranging from 0–1050 µg/mL (b), and Hg/Cd/As/Cr ranging from 1–128 µg/mL (c)
“+”: LB medium with bacterial inoculation; “–”: uninoculated LB medium; Bacterial growth was evidenced by increased turbidity of the medium relative to the negative control (–) or by the appearance of a white pellicle on the surface.
4. DISCUSSION
The offshore coral islands of Khanh Hoa Province represent some of the most extreme terrestrial environments in Vietnam, characterized by saline and arid soils combined with intense solar radiation. In addition to these abiotic constraints, the oligotrophic nature of the ecosystem requires indigenous microorganisms not only to withstand multiple environmental stresses but also to develop efficient metabolic strategies to exploit the limited nutrient resources available. Building on previous findings of salt tolerance and EPS production in B. velezensis TSD5 [5], this study demonstrates that the strain also possesses additional traits, including hydrocarbon degradation, hydrolysis of organic macromolecules, plant growth promotion, and tolerance to salt and heavy metal stress. Such multifunctional properties not only enhance the ecological fitness of the bacterium itself but also support the resilience of soil microbial communities and facilitate plant survival and growth under extreme environmental conditions.
B. velezensis TSD5 exhibited multifunctional traits with both ecological and applied significance. This strain synthesizes IAA at a concentration of 12.76 mg/L, thereby reinforcing its potential as a promising biofertilizer for saline and nutrient-poor soils. Moreover, the observed IAA level suggests that TSD5 likely utilizes a tryptophan-dependent biosynthetic pathway, consistent with previous reports of tryptophan-derived IAA production in Bacillus spp. [12]. Although the Salkowski assay detects total indole-related compounds and has limited specificity compared with chromatographic methods, it remains a widely used preliminary approach for assessing IAA production. These exploratory results provide a basis for future studies employing more accurate quantitative analyses and optimized conditions for IAA production. Strong cellulase and lipase activities, along with moderate protease and amylase production compared with reference strains (B. velezensis HMB26553 [6], B. velezensis QA2 [17], Bacillus spp. [15], and B. amyloliquefaciens Ba-BPD1 [16], reflect a broad substrate-degrading capacity. This ability is particularly important in coral island soils, where nutrient sources are scarce and mainly derived from leaf litter and plant debris. By hydrolyzing complex organic macromolecules into bioavailable forms, TSD5 contributes directly to nutrient turnover, enhances soil fertility, and promotes plant–microbe interactions.
Crude oil and its derivatives are persistent pollutants that cause severe and long-lasting ecological damage; therefore, sustainable remediation strategies are critically required [19]. Biodegradation by hydrocarbon-degrading bacteria has emerged as an efficient and environmentally friendly alternative to conventional methods, particularly when biosurfactant production enhances hydrocarbon solubilization and bioavailability [20]. In this study, B. velezensis TSD5 exhibited hydrocarbon-degrading capacity, with displacement halos of 16.65 mm on diesel and 27.05 mm on crude oil, consistent with previous reports of strong hydrocarbon metabolism in B. velezensis, including the removal of 26 out of 42 components of engine oil, with substantial reduction of the remaining fractions [7]. The hydrocarbon-degrading activity of TSD5 is consistent with biosurfactant-assisted mechanisms reported in oil-degrading bacteria. As shown by Lee et al. [20], biosurfactants markedly reduce surface tension, enhance oil spreading and emulsification, and desorb crude oil from sediments, thereby increasing hydrocarbon bioavailability for microbial uptake and metabolism. The strong oil-spreading zone and large degradation halos observed in TSD5 suggest that similar biosurfactant-mediated emulsification and subsequent metabolic breakdown likely contribute to its crude-oil and diesel-degrading capacity.
Beyond its degradative capacity, strain TSD5 tolerated 12.5% NaCl, 10% MgSO₄, and heavy metals such as Pb (900 µg/mL), comparable to B. velezensis DTA1. Notably, its tolerance to Fe (750 µg/mL) and Hg (16 µg/mL) exceeded that of DTA1 (600 µg/mL and 2 µg/mL, respectively), whereas its resistance to Zn, Cd, As, and Cr was lower than that reported for DTA1 [3]. Its resistance profile is also consistent with other heavy-metal-tolerant Bacillus strains, such as C3-3, which withstand multiple metals including Cd, Co, Mn, and Ni at millimolar concentrations [8, 9]. Salt tolerance and resistance to multiple heavy metals have been well documented in Bacillus strains. These traits are generally attributed to the presence of salt-stress–responsive genes, metal-efflux transporters, and the ability to accumulate compatible solutes. Notably, many Bacillus strains also produce EPS, whose synthesis is often upregulated under stress conditions, thereby promoting the formation of protective biofilms that shield cells from environmental stressors [3, 8].
In conclusion, B. velezensis TSD5 exhibits a suite of multifunctional traits, including tolerance to salt and heavy metals, hydrocarbon degradation, extracellular enzyme activities, and phytohormone synthesis. These features not only enhance microbial survival and nutrient cycling in nutrient-poor coral island soils but also highlight the potential of B. velezensis TSD5 as a microbial inoculant for biofertilization, organic matter turnover, petroleum-pollution remediation, and heavy-metal bioremediation. Therefore, B. velezensis TSD5 represents a valuable microbial resource for sustainable agriculture and environmental restoration in saline, degraded, and contaminated ecosystems.
5. CONCLUSION
Bacillus velezensis TSD5 exhibited a unique combination of adaptive and functional traits, including high tolerance to 12.5% NaCl, 10% MgSO₄, and heavy metals such as Pb (900 µg/mL) and Fe (750 µg/mL). The strain produced substantial levels of indole-3-acetic acid (12.76 mg/L), along with strong cellulase and lipase activities and moderate protease and amylase production, reflecting broad metabolic versatility for nutrient cycling in nutrient-poor coral island soils. Moreover, TSD5 demonstrated hydrocarbon-degrading capacity with displacement halos of 27.05 mm on crude oil and 16.65 mm on diesel, highlighting its potential in petroleum pollution mitigation. Collectively, these multifunctional traits highlight the potential of B. velezensis TSD5 as a promising candidate for the reclamation of saline and nutrient-poor soils, as well as the restoration of polluted environments, particularly under the harsh conditions of offshore coral islands. However, these findings represent only preliminary studies, and further experiments and field evaluations are required to assess the strain’s potential for heavy metal and hydrocarbon remediation, as well as its effectiveness in the restoration of saline and nutrient-poor soils.
Acknowledgments: This research was supported by the Joint Vietnam–Russia Tropical Science and Technology Research Center (No. SH.Đ2.06/25).
Statement on the use of Generative AI: The authors declare that AI tools were used only for language editing/formatting, and not for generating scientific content. All data, analyses, and interpretations were performed and verified by the authors, who take full responsibility for the manuscript.
Author contributions: Le Thi Hue conceived and designed the experiments, performed data analysis, and drafted the manuscript. Dinh Hoang Tuan carried out the experimental work; Vu Duy Nhan, Ngo Cao Cuong, Nguyen Huu Tung, Ngo Thi Trang, Ha Quoc Duong, and Dang Thi Thuy Duong provided technical assistance and experimental support.
Conflict of interest statement: The authors declare that there are no conflicts of interest related to this article.
References
2. Le Thi Hue, Vu Duy Nhan, Le Mai Huong, and Do Thi Tuyen, Selection of salt-tolerant bacterial strains capable of producing exopolysaccharide from coral islands in Khanh Hoa, TNU Journal of Science and Technology, Vol. 229, No. 13, pp. 386-393, 2024. DOI: org/10.34238/tnu-jst.10566
3. H.T. Le et al., Genomic insights into salt-tolerant, exopolysaccharide-producing Bacillus velezensis DTA1 isolated from coral island soil in Vietnam: Implications for soil remediation. One Ecosystem, Vol. 10, pp. e158806, 2025. DOI: 10.3897/oneeco.10.e158806
4. T.H. Le, H.T. Dinh, M.H. Le, C.T. Nguyen, and Q.C. Hoang, Characterization and exopolysaccharide production of Bacillus velezensis DTA1 from Vietnamese atoll soil, Journal of Degraded and Mining Lands Management, Vol. 12, No. 4, pp. 8305-8314, 2025. DOI: 10.15243/jdmlm.2025.124.8305
5. T.H. Le et al., Amending coral soil using exopolysaccharide from salt-tolerant Bacillus velezensis TSD5 bacteria from an atoll in Vietnam, Journal of Applied Biology & Biotechnology, Vol. 13, No. 5, pp. 151-162, 2025. DOI: 10.7324/JABB.2025.229116
6. Z. Su et al., Functional analyses of the Bacillus velezensis HMB26553 genome provide evidence that its genes are potentially related to the promotion of plant growth and prevention of cotton Rhizoctonia damping-off, Cells, Vol. 12, No. 9, pp. 1301-28, 2023. DOI: 10.3390/cells12091301
7. S. Ullah et al., Biodegradation of petroleum by bacteria isolated from fishes of Indian Ocean, Brazilian Journal of Biology, Vol. 82, pp. e244703, 2021. DOI: 10.1590/1519-6984.244703
8. A.C. Herrera-Calderon et al., Metagenomic and genomic analysis of heavy metal-tolerant and-resistant bacteria in resource islands in a semi-arid zone of the Colombian Caribbean, Environmental Science and Pollution Research, Vol. 31, No. 4, pp. 5596-5609, 2024. DOI: 10.1007/s11356-023-30253-w
9. M. Shahid et al., Stress-tolerant endophytic isolate Priestia aryabhattai BPR-9 modulates physio-biochemical mechanisms in wheat (Triticum aestivum L.) for enhanced salt tolerance, International Journal of Environmental Research and Public Health, Vol. 19, No. 17, pp. 10883, 2022. DOI: 10.3390/ijerph191710883
10. M.M. Stancu, Investigating the potential of native soil bacteria for diesel biodegradation, Microorganisms, Vol. 13, No. 3, pp. 564, 2025. DOI: 10.3390/microorganisms13030564
11. F. Al-Otibi, R.M. Al-Zahrani, and N. Marraiki, The crude oil biodegradation activity of Candida strains isolated from oil-reservoirs soils in Saudi Arabia, Scientific Reports, Vol. 12, No. 1, pp. 10708, 2022. DOI: 10.1038/s41598-022-14836-0
12. S. Lebrazi, K. Niehaus, H. Bednarz, M. Fadil, M. Chraibi, and K. Fikri-Benbrahim, Screening and optimization of indole-3-acetic acid production and phosphate solubilization by rhizobacterial strains isolated from Acacia cyanophylla root nodules and their effects on its plant growth, Journal of Genetic Engineering and Biotechnology, Vol. 18, No. 1, pp. 71, 2020. DOI: 10.1186/s43141-020-00090-2
13. Dang Thi Thanh Tam, Tran Thi Yen and Nguyen Thanh Huyen, Characterization of potential cellulose-degrading bacteria isolated from by-products of wood processing, Vietnam Journal of Agricultural Sciences, Vol. 21, No. 8, pp. 1028-1036, 2023.
14. Le Huu Nhan, Nguyen Thi Anh Tuyet, and Nguyen Thi Phi Oanh, Isolation and selection of bacteria capable of degrading and performing chemotaxis towards lubricating oil, Can Tho University Journal of Science, Vol. 57, No. 1, pp. 35-44, 2021. DOI: 10.22144/ctu.jvn.2021.006
15. V.H.T. Pham, J. Kim, S. Chang, and W. Chung, Investigation of lipolytic-secreting bacteria from an artificially polluted soil using a modified culture method and optimization of their lipase production, Microorganisms, Vol. 9, No. 12, pp. 2590, 2021. DOI: 10.3390/microorganisms9122590
16. F.C. Hsieh, S.S. Kao, Novel strain of Bacillus amyloliquefaciens and its use, U.S. Patent US20100143316A1, 2010.
17. I. Mahdi, A. Allaoui, N. Fahsi, and L. Biskri, Bacillus velezensis QA2 potentially induced salt stress tolerance and enhanced phosphate uptake in quinoa plants, Microorganisms, Vol. 10, No. 9, pp. 1836, 2022. DOI: 10.3390/microorganisms10091836
18. M. Rani, J.T. Weadge, and S. Jabaji, Isolation and characterization of biosurfactant-producing bacteria from oil well batteries with antimicrobial activities against food-borne and plant pathogens, Frontiers in Microbiology, Vol. 11, pp. 64, 2020. DOI: 10.3389/fmicb.2020.00064
19. N. Das, P. Chandran, Microbial degradation of petroleum hydrocarbon contaminants: An overview, Biotechnology research international, Vol.2011, No. 1, pp. 941810, 2011. DOI: 10.4061/2011/941810
20. D.W. Lee et al., Biosurfactant-assisted bioremediation of crude oil by indigenous bacteria isolated from Taean beach sediment, Environmental pollution, Vol. 241, pp. 254-264, 2018. DOI: 10.1016/j.envpol.2018.05.070